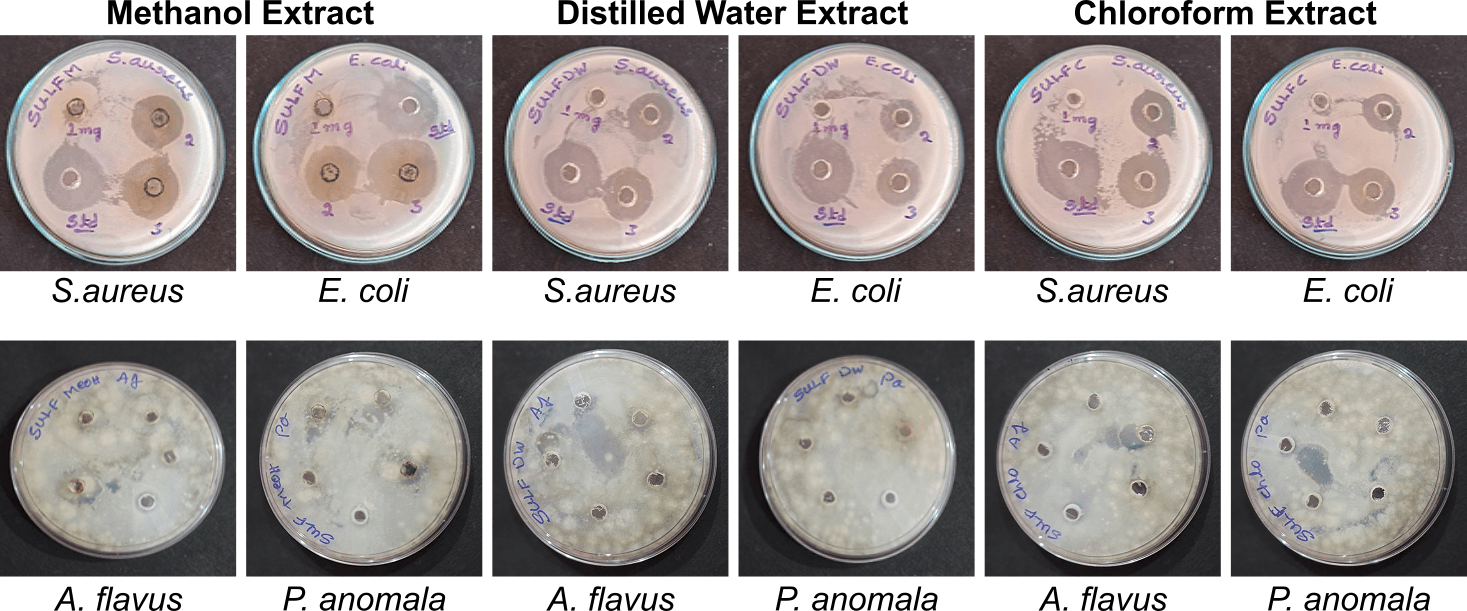
Figure 5. Antimicrobial activity of methanolic, distilled water, and chloroform leaf extracts of Strobilanthes urens.

RESEARCH ARTICLE
Phytochemical Profiling and Biological Activities of Strobilanthes urens (B. Heyne ex Roth) J.R.I. Wood. Leaf Extract (Acanthaceae)
Sciences of Phytochemistry|Vol. 4, Issue 2, pp. 107-115 (2025)
Received
Jun 1, 2025Revised
Aug 26, 2025Accepted
Sep 28, 2025Published
Oct 31, 2025
Abstract
Introduction
All over the world, plants are essential to human life. Their secondary metabolites play a vital role. A large number of plants are used to treat numerous ailments. According to the WHO, eighty percent of the population in the world depends upon medicine, 80 to 85% of medicine is extracted from medicinal plant extracts (1). Herbal medicines treat and cure many diseases and health conditions through traditional systems such as Unani, Ayurveda, and Siddha. Strobilanthes urens (B. Heyne ex Roth) J.R.I. Wood is a genus of flowering plants in the family Acanthaceae. The native range of this species is western India. It is a subshrub and grows primarily in the seasonally dry tropical biome. Acanthaceae comprises 346 genera and 4300 species, most of which are herbs, shrubs, and vines. The plants of this family are cosmopolitan and distributed in the Old and New World. And present in Africa, Central America, Malaysia, and Indonesia, with few species extending to South Europe, Japan, the Southern coast of New Holland, and Southern to the Cape of Good Hopes, In India, Acanthaceae genera are peculiar to the Southern parts, Indian Archipelago and Malayan Peninsula but have spread from Sutlej to Sylhet and lower ranges of Himalayas (2). The plants have many therapeutic uses, such as treating inflammation, infections, wounds, skin lesions, diarrhea, scabies, leprosy, ulcers, and snake bites (3).
Plant-based medicine has become of great interest owing to its versatile applications. Medicinal plants are the source of drugs in conventional systems of medicine, including present-day medications, food supplements, nutraceuticals, folk medicines, pharmaceuticals, and synthetic drugs (4). The plant has been traditionally used to treat bone fractures, skin conditions, urinary diseases, and allergies (5). Strobilanthes hamiltoniana exhibits potent pharmacological activities, including antibacterial and anthelmintic activities (6). The present research aims to study the potent phytochemicals (Qualitative and Quantitative), their antimicrobial, antioxidant, and anticancer activities.
Materials and Methods
Collection of Plant Material
The collection of S. urens (B. Heyne ex Roth) J.R.I. Wood is from Kalgi village, Kalburgi District, Karnataka, India, identified by A N Sringeswara, curator, Mahatma Gandhi Botanical Garden, University of Agricultural Sciences, KGVK Bangalore, collection Number 009, Accession number UASB 5720. The plant and its part identified can be seen in Figure 1.
Preparation of Leaf Extract
The fresh plant leaves were washed with ionized water to remove surface impurities and unwanted debris, then air-dried in a shaded area to ensure proper moisture removal. The dried material was ground into a fine powder using a blender. Approximately 25 g of the leaf powder were packed into filter paper and subjected to Soxhlet extraction using 250 mL each of distilled water, methanol, and chloroform.

Proximate Compositions
The dried plant powder was used to analyze moisture content, which was determined by drying the biomass for 10 h at 100 °C. Lipid content was estimated using the phenol-sulfuric acid method, carbohydrate content by the Kjeldahl method, and protein content according to AOAC procedures. Ash content was measured in a muffle furnace at 550 °C to determine the nutritive value (7).
Total Phenolic Contents
The total phenolic content (TPC) was estimated using the Folin–Ciocalteu (FC) reagent, with gallic acid as the standard antioxidant. A 100 µL aliquot of appropriately diluted extract was mixed with 0.5 mL of FC reagent and incubated at room temperature for 10 min. Then, 2 mL of 7% Na₂CO₃ solution was added. The mixture was boiled for 1 min, after which the absorbance was measured at 750 nm using a spectrophotometer (Shimadzu UV-1800, Kyoto, Japan). The results were expressed as micrograms of gallic acid equivalents (µg GAE) (8).
Total Flavonoid Estimation
The total flavonoid content was estimated using 200 µL of the sample mixed with 5 mL of chromogen reagent, 25 mL of methanol, 25 mL of concentrated HCl, and 0.1% cinnamaldehyde solution in a cooled mixture totaling 75 mL. After incubation for 10 min, the absorbance was measured at 640 nm. The flavonoid content was expressed as micrograms of catechin equivalents (µg CE) per milligram of extract (9).
Total Alkaloid Estimation
A 200 µg portion of the sample was dissolved in 1 mL of 2N HCl, then filtered and washed with 10 mL of chloroform. Similarly, atropine standard solutions (20, 40, 60, 80, and 100 µg/mL; Sigma Chemical, USA) were prepared. To each solution, 5 mL of bromocresol green (BCG) reagent (prepared by dissolving 69.8 mg of BCG in 3 mL of 2N NaOH and diluting with distilled water) and phosphate buffer (pH 4.7) were added, and the total volume was made up to 10 mL. The absorbance was measured at 470 nm using a spectrophotometer, with a blank prepared under the same conditions but without atropine or sample. The alkaloid content was expressed as micrograms of atropine equivalents (µg AE) per milligram of extract.
Total Tannins Estimations
The tannin content was estimated using 0.05 mL of the sample, and the volume was adjusted to 0.5 mL with distilled water. Then, 0.25 mL of 1N Folin–Ciocalteu reagent was added, followed by 1.25 mL of 20% sodium carbonate solution. The mixture was vortexed and incubated for 40 min at room temperature. Absorbance was measured at 725 nm using a spectrophotometer. The tannin content was expressed as micrograms of tannic acid equivalents (µg TAE) per milligram of extract (10).
Qualitative Phytochemical Analysis
A preliminary qualitative phytochemical analysis was conducted for different secondary metabolites (Phenols, Alkaloids, Flavonoids, Tannins, Terpenoids, Saponins, Glycosides, Steroids, Proteins, Carbohydrates) using specific chemical reagents (11).
Antimicrobial Activity
Antimicrobial activity was evaluated using the agar diffusion method (12). The samples were tested against gram-positive Staphylococcus aureus (MTCC-7443) and gram-negative Escherichia coli (MTCC-7410), with incubation at 37 °C for bacterial strains. The inoculum was adjusted to approximately 5 × 10⁵ CFU/mL using sterile saline solution. Samples were dissolved in DMSO at a concentration of 20 mg/mL to prepare the stock solution and loaded into wells at concentrations ranging from 200 µg to 800 µg. Mueller-Hinton agar was used for bacterial cultures, and Czapek-Dox agar was used for fungal species. The fungi, Aspergillus flavus (MTCC-9606) and Pichia anomala (MTCC-237), were incubated at 28 °C for 72 h. After incubation, the diameters of the inhibition zones (mm) were measured.
GC-MS Analysis
Gas chromatography–mass spectrometry (GC–MS) analysis was performed to determine the phytochemical constituents. The procedure was carried out using a Shimadzu QP2010S system operating in electrospray ionization (ESI) mode, equipped with an ELITE-5MS capillary column (film thickness: 0.25 µm; length: 30 m; internal diameter: 0.25 mm). The GC oven temperature was initially set at 80 °C and programmed to increase to 450 °C at a rate of 20 °C/min to achieve effective analyte separation. Sample injection was conducted using a 2 mm direct injection technique. Compound identification was based on the comparison of relative retention times and mass spectral data with reference spectra from the National Institute of Standards and Technology (NIST) library. The analytical procedure followed established protocols to ensure accurate compound characterization, as described by Chakraborty et al. (2022) (13).
FTIR Analysis
Fourier Transform Infrared Spectroscopy (FTIR) was employed to analyze the bioactive constituents. The analysis was performed using a spectrophotometer (Thermo Fisher Scientific, Waltham, MA, USA). The dried powder of biosynthesized nanoparticles was mixed with potassium bromide (KBr) and compressed into pellets. The spectra were recorded within the range of 400–4000 cm⁻¹ to identify characteristic infrared absorption bands. The presence of functional biomolecules in the sample was confirmed through spectral analysis, facilitating comprehensive characterization of the nanoparticles’ chemical composition (14).
DPPH Assay
The radical scavenging activity of the samples was evaluated using the stable DPPH radical, as previously described (15). Different concentrations of the samples (0–100 µg/mL) were mixed with 2 mL of DPPH solution (100 µM) and 3 mL of methanol. The mixture was incubated at room temperature in the dark for 45 min. After incubation, the absorbance was measured at 517 nm using a spectrophotometer (Shimadzu UV-1800, Kyoto, Japan) against a blank (without sample or standard). The free radical scavenging capacity of the samples was calculated and expressed as IC₅₀ values, relative to vitamin C as the standard.
Cytotoxicity Property
The IC₅₀ value was determined using the MTT assay. Cultured cells (1 × 10⁵) were seeded into 96-well plates and incubated for 48 h at 37 °C in a 5% CO₂ incubator. After incubation, the monolayer was washed with fresh medium, and 100 µL of different test concentrations of the samples was added to each well. The cells were further incubated under the same conditions. Subsequently, the medium was removed, and 100 µL of MTT solution was added to each well, followed by incubation at 37 °C for 4 h. After the supernatant was discarded, 100 µL of DMSO was added to each well and incubated for 10 min to solubilize the formazan crystals. The optical density was measured at 590 nm. The percentage of cell growth inhibition was calculated, and the IC₅₀ values were determined from the dose–response curve (16).
Results and Discussion
Proximate Composition
The proximate analysis of S. urens leaf extract revealed the following composition: total protein, 28.62 ± 2.57%; total carbohydrates, 17.85 ± 1.24%; total lipids, 12 ± 0.75%; total ash, 14.26 ± 0.59%; moisture content, 2.35 ± 0.24%; and nutritive value, 233.88 kcal.
In comparison, Strobilanthes crispus leaves were reported to have an ash content of 21.6%, with mineral concentrations of calcium (5185 mg/100 g), potassium (10,900 mg/100 g), sodium (2953 mg/100 g), iron (255 mg/100 g), and phosphorus (201 mg/100 g) in notably high amounts (17). Strobilanthes crispa Blume was reported to contain relatively low levels of protein, carbohydrates, fat, moisture, ash, and minerals (18). Similarly, Strobilanthes auriculata Nees was found to contain protein (8.40 mg/100 g), amino acids (2.25 mg/100 g), tannins (4.80 mg/100 g), crude lipids (0.99 mg/100 g), and crude fiber (0.14 mg/100 g) (19). Furthermore, S. crispus was reported to have moisture (82.43 ± 0.94%), ash (6.97 ± 0.34%), carbohydrates (2.94 ± 0.92%), protein (4.56 ± 0.12%), and fat (3.05 ± 0.41%) (20).
No. | Phytochemical tests | SULF M | SULF DW | SULF CHL |
1 | Phenols | + | + | + |
2 | Alkaloids | + | + | - |
3 | Flavonoids | + | + | + |
4 | Tannins | + | + | - |
5 | Terpenoids | + | - | + |
6 | Saponins | + | + | - |
7 | Glycosides | + | + | - |
8 | Steroids | - | - | - |
9 | Proteins | + | + | + |
10 | Carbohydrates | + | + | + |
Note: (+) = present and (-) = absent. | ||||
No. | Samples | Polyphenols (µg/mg GAE) | Flavonoids (µg/mg QE) | Tannins (µg/mg TAE) | Alkaloids (µg/mg AE) |
1 | SULF DW | 235.50 ± 5.44 | 135.57 ± 8.88 | 28.88 ± 2.89 | 105.71 ± 5.20 |
2 | SULF M | 270.50 ± 3.30 | 260.57 ± 3.93 | 130.03 ± 7.02 | 211.79 ± 1.99 |
3 | SULF Chl | 199.25 ± 2.50 | 150.15 ± 5.63 | 2.45 ± 3.51 | 53.06 ± 5.85 |
Peak# | Retention Time | Area | Area% | Similarity | Base m/z | Compound Name |
1 | 3.842 | 1646387 | 2.15 | 98 | 96.00 | Furfural |
2 | 5.687 | 1058709 | 1.38 | 98 | 110.05 | Furfural <5-methyl-> |
3 | 6.844 | 442838 | 0.58 | 96 | 79.05 | Benzyl alcohol |
4 | 6.981 | 648737 | 0.85 | 75 | 113.00 | Thiofuran <2-methyl-, 3-methyl-> |
5 | 7.614 | 395493 | 0.52 | 83 | 43.00 | Pineapple ketone |
6 | 9.670 | 2762250 | 3.60 | 94 | 97.00 | Hydroxymethyl furfural |
7 | 11.987 | 438285 | 0.57 | 66 | 136.05 | Copaen-4-alfa-ol |
8 | 13.821 | 3136242 | 4.09 | 65 | 73.05 | Decamethylcyclopentasiloxane |
9 | 14.530 | 1534616 | 2.00 | 73 | 73.05 | Tridecanol |
10 | 14.621 | 1261145 | 1.65 | 53 | 73.05 | Tridecane |
11 | 17.451 | 348926 | 0.46 | 96 | 68.05 | Neophytadiene |
12 | 17.521 | 355595 | 0.46 | 92 | 43.05 | Phytone |
13 | 18.793 | 4311986 | 5.63 | 46 | 73.05 | Decamethylcyclopentasiloxane |
14 | 19.358 | 1395407 | 1.82 | 96 | 73.00 | Hexadecanoic acid |
15 | 21.223 | 2949334 | 3.85 | 54 | 73.05 | Decamethylcyclopentasiloxane |
16 | 21.894 | 1446147 | 1.89 | 92 | 82.05 | Neophytadiene |
17 | 22.214 | 455586 | 0.59 | 95 | 67.05 | Linoleic acid |
18 | 22.319 | 1033923 | 1.35 | 89 | 79.05 | Linolenate |
19 | 28.165 | 1204901 | 1.57 | 69 | 277.10 | Phytol |
20 | 38.235 | 1249610 | 1.63 | 67 | 81.10 | Torulosol |
21 | 38.584 | 4600200 | 6.00 | 65 | 83.10 | Larixol |
22 | 39.440 | 5567702 | 7.26 | 66 | 145.10 | Torulosol |
Preliminary Qualitative Phytochemical Analysis
The preliminary qualitative phytochemical analysis (PQPA) of S. urens leaf extract revealed the presence of alkaloids, phenols, tannins, flavonoids, terpenoids, saponins, glycosides, steroids, and proteins. These compounds were detected across all three solvent extracts (methanol, water, and chloroform), except steroids in methanol; terpenoids and steroids in distilled water; and alkaloids, tannins, saponins, glycosides, and steroids in chloroform (Table 1).
Similarly, S. alternata leaves have been reported to contain alkaloids, saponins, flavonoids, tannins, and hydrogen cyanide, with additional evaluation of their anti-nutritional components (21). Strobilanthes integrifolius leaves were shown to contain alkaloids, carbohydrates, glycosides, saponins, proteins, phytosterols, fixed oils, phenolics, and flavonoids, while its stems exhibited the presence of alkaloids, carbohydrates, phytosterols, terpenoids, phenolics, and flavonoids. Likewise, Strobilanthes blume leaves were reported to contain carbohydrates, phytosterols, terpenoids, fixed oils, and phenolics, and its stems to contain alkaloids, carbohydrates, phytosterols, terpenoids, phenolics, and flavonoids (22).
Quantitative Phytochemical Estimation
The quantitative phytochemical estimation (QPE) of S. urens leaf extract revealed that the total polyphenol content was 235.50 ± 5.44 µg/mg in distilled water, 270.50 ± 3.30 µg/mg in methanol, and 199.25 ± 2.50 µg/mg in chloroform. The total flavonoid content was 135.57 ± 8.88 µg/mg in distilled water, 260.57 ± 3.93 µg/mg in methanol, and 150.15 ± 5.63 µg/mg in chloroform. The total tannin content was 28.88 ± 2.89 µg/mg in distilled water, 130.03 ± 7.02 µg/mg in methanol, and 2.45 ± 3.51 µg/mg in chloroform. The alkaloid content was 105.71 ± 5.20 µg/mg in distilled water, 211.79 ± 1.99 µg/mg in methanol, and 53.06 ± 5.85 µg/mg in chloroform (Table 2).
S. alternata has been reported to contain phytates, tannins, oxalates, and cyanogenic glycosides (23). Strobilanthes kunthiana was reported to possess tannins, phenolics, and flavonoids (24). Similarly, Strobilanthes heyneana root extract exhibited a total phenolic content of 125.53 ± 2.29 µg/mg and a flavonoid content of 32.79 ± 0.62 µg/mg (25).


GC-MS Analysis
The GC–MS analysis of the methanolic extract of S. urens revealed a total of 45 bioactive compounds with distinct retention times and area percentages (Table 3 and Figure 2). The major compounds identified include Furfural (RT 3.842), Pineapple ketone (RT 7.614), 5-Methylfurfural (RT 5.687), Benzyl alcohol (RT 6.844), Decamethylcyclopentasiloxane (RT 13.821), Neophytadiene (RT 17.451), Phytone (RT 17.452), n-Hexadecanoic acid (RT 19.358), Linoleic acid (RT 22.214), Phytol (RT 28.165), Torulosol (RT 38.235), and Larixol (RT 38.584). The corresponding chemical structures of these compounds are shown in Figure 3.
Similarly, GC–MS analysis of S. crispus extracts reported 18 compounds in the leaves, 23 compounds in the stem, and 12 compounds in the roots, including hexadecanoic acid, 9-octadecanamide, eicosane, squalene, cholesterol, vitamin E, campesterol, stigmasterol, γ-sitosterol, lupeol, and betulin (26). Strobilanthes glutinosus chloroform and n-hexane extracts revealed 81 compounds, such as methyl esters, n-hexadecanoic acid, lupeol, linoleic acid, stigmasterol, γ-sitosterol, and linoelaidic acid, many of which have been reported to exhibit antioxidant, antidiabetic, anti-inflammatory, antimicrobial, antiprotozoal, and anticancer activities (27).
FTIR Analysis
FTIR analysis was performed to identify the functional groups of bioactive components based on peak values, allowing classification of compound types (Figure 4). The detected peaks ranged from 4000 cm⁻¹ to 600 cm⁻¹. The major absorption bands corresponded to N–O–H, N–H, C–H, N=C=S, C=C, O–H bending, and C–F stretching, which indicate the presence of intermolecular vibrations, secondary amines, alkanes, isothiocyanates, conjugated alkenes, nitro compounds, carboxylic acids, and fluoro compounds.
Additional peaks such as O–H, C–H, O=C=O, S–C≡N, C=C, S=O, and CO–O–CO were associated with alcohols, aldehydes, carboxylic acids, thiocyanates, cyclic alkanes, sulfonyl chlorides, and anhydrides. The O–H, N–H, O=C=O, C=C, C–H, S=O, C–N, and C–O stretching bands corresponded to alcohols, secondary amines, carbon dioxide, conjugated alkenes, alkanes, sulfonyl chlorides, aromatic amines, and primary alcohols, respectively, in methanol, water, and chloroform extracts.
S. crispus leaves were previously reported to exhibit functional groups such as C–Cl (halo compounds), C–N (amines), C=C (alkenes), N–H (aliphatic primary amines), M–O (metal–oxygen bonds), C–O (tertiary alcohols), and O–H stretching (alcohol groups) (28). Similarly, Strobilanthes ciliatus Nees showed characteristic peaks for S=O (sulfates), C–H bending (alkanes), C–O (alkanes), N–H (amines), C–H (carboxylic acids), C–H (aryl ketones), N–H (amides), C=O (amides), =C–H (aldehydes), and C=O (ketones) (29).
Antioxidant Activity by DPPH Assay
The antioxidant activity of S. urens extracts revealed IC₅₀ values of 79.23 ± 3.7 µg/mL and 237.00 ± 12.37 µg/mL for the methanol and distilled water extracts, respectively, while the chloroform extract showed no detectable activity. Vitamin C was used as a standard (Table 4). The strong antioxidant potential observed in the methanolic extract may be attributed to its high flavonoid content, as flavonoids are known to exhibit antioxidant activity primarily through metal chelation mechanisms (35).

No. | Samples | DPPH (IC50 µg/ml) |
1 | SULF M | 79.23 ± 3.78 |
2 | SULF DW | 237.00 ± 12.37 |
3 | SULF CHL | ND |
4 | Std (Vit-C) | 26.21 ± 2.84 |
Note: Not detected (ND) indicates there is no activity found in the tested concentration. | ||
S. kunthiana has been reported to show significant antioxidant activity, with IC₅₀ values of 19.97 ± 1.30 µg/mL and 20.97 ± 1.74 µg/mL in the DPPH assay, and 4.36 ± 0.38 µg/mL in the ABTS assay (27). Similarly, S. crispus leaves demonstrated potent radical-scavenging activity, with IC₅₀ values of 44.1, 58.2, and 78.3 µg/mL as determined by the DPPH assay (30).
Antimicrobial Activity
The antimicrobial activity of S. urens extracts demonstrated clear zones of inhibition at the tested concentrations across all three solvent extracts. The bacterial strains used for antibacterial testing were S. aureus and E. coli, while the fungal strains tested were A. flavus and P. anomala. No antifungal activity was observed at the tested concentrations. Kanamycin was used as the standard control (see Figure 5 and Supplementary Table 1).
Previous studies on S. crispus and Clianthus nutans reported activity against a total of eight Gram-positive and eight Gram-negative bacteria using the agar diffusion method with ethanol, acetone, and chloroform extracts. Among these, Pseudomonas aeruginosa exhibited the largest zone of inhibition, indicating strong susceptibility. This suggests that certain phytochemicals present in the extracts may specifically target P. aeruginosa, contributing to its pronounced antibacterial effect (31).
Cytotoxicity by MTT Assay
The cytotoxicity assay results revealed that the percentage of cytotoxicity against the MCF-7 cell line showed IC₅₀ values of 188.10 ± 39.99 µg/mL and 88.18 ± 8.29 µg/mL, while the HepG2 cell line exhibited IC₅₀ values of 129.34 ± 3.94 µg/mL and 156.38 ± 5.64 µg/mL. Doxorubicin was used as the standard control (Figures 6, 7, and Supplementary Table 2).
The methanolic extract of S. crispus was previously reported to show limited cytotoxicity against HepG2 cells at concentrations ranging from 31.25 µg/mL to 250 µg/mL, indicating no significant cell death (32). In contrast, S. crispa leaf extracts in ethyl acetate and chloroform demonstrated potent cytotoxic activity against the HepG2 cell line, with IC₅₀ values of 38.8 µg/mL (33). Furthermore, S. crispus stem and leaf extracts exhibited cytotoxic activity against the MCF-7 cell line, with IC₅₀ values of 23 µg/mL and 38 µg/mL for the leaf extract, while the stem extract showed higher IC₅₀ values of 74–86 µg/mL (34). Lower IC₅₀ values indicate higher potency due to stronger interactions with cellular targets, whereas higher IC₅₀ values reflect weaker cytotoxic potential (35).

Conclusion
The present study reveals that the various phytochemicals present in S. urens (B. Heyne ex Roth) J.R.I. Wood. These are linked to various pharmacological and biological activities. The various compounds identified might be a good source of novel drugs as the GC-MS analysis shows a good anti-cancer potential from MCF-7 and HepG2 show good therapeutic values in crude extracts against various ailments. From the present research, the Torulosol bioactive compound shows potent activity. It is concluded that the methanol crude extract shows a promising tool in the pharmaceutical and therapeutic applications. Further study is needed to isolate, characterize, and determine the pharmacological activities of compounds reported in our study.
Abbreviations
SULF M = Strobilanthes urens methanol extract; SULF DW = Strobilanthes urens distilled water extract; SULF CHL = Strobilanthes urens chloroform extract; SULF = Strobilanthes urens leaf; GC-MS = Gas chromatography mass spectroscopy.
Declarations
Acknowledgment
The authors gratefully acknowledge the P.G. Department of Studies in Botany, Davangere University, Shivagangotri, Davangere, Karnataka, India; Dr. Sudharshan B. L., Cheliyan Biotech Solutions, Mysore; and the Sophisticated Analytical Instrumentation Facility (SAIF), Karnatak University, Dharwad, for providing laboratory facilities to conduct the experiments.
Conflict of Interest
The authors declare no conflicting interest.
Data Availability
The unpublished data is available upon request to the corresponding author.
Funding Information
The author(s) declare that no financial support was received for the research, authorship, and/or publication of this article.
Supplemental Material
The supplementary data can be downloaded at the link: https://etflin.com/file/document/202510310200431243264911.docx
References
- Ghasemzadeh A, Jaafar HZ, Rahmat A. Phytochemical constituents and biological activities of different extracts of Strobilanthes crispus (L.) Bremek leaves grown in different locations of Malaysia. BMC Complement Altern Med. 2015;15:1–10.
- Rattan R. Bioactive phytochemicals from Acanthaceae – Mini review. J Emerg Techn Innov Res. 2023;10(5):580–5.
- Sene M, Mandal A, Dey SK. Antimicrobial activity of ethanolic extracts of eight medicinal plants used in traditional medicine in India. 2015.
- Neelambika HS, Sampath KKK, Vindhya K, Leelavathi S. Preliminary phytochemical investigations of Blepharis maderaspatensis (L.) Heyne ex Roth and Blepharis molluginifolia Pers., whole plant. 2014.
- Vijayalakshmi S, Kripa KG. Therapeutic uses of plants of the genus Blepharis – A systematic review. Int J Pharma Bio Sci. 2016;7:B236–43.
- Baby AA, Raphael KR. Medicinal properties of a garden plant Strobilanthes hamiltoniana (Steud.) Bosser & Heine. Asian J Pharm Clin Res. 2018;11(11):256–8.
- Sarala P. Distribution, nutritive value, and mineral composition of a few medicinal plants of Shimoga district, Karnataka [dissertation]. Shimoga: Kuvempu University; 2008.
- Singleton VL, Orthofer R, Lamuela-Raventós RM. Analysis of total phenols and other oxidation substrates and antioxidants using the Folin–Ciocalteu reagent. In: Methods in Enzymology. Vol 299. Academic Press; 1999. p. 152–78.
- Delcour JA, Varebeke DJD. A new colorimetric assay for flavonoids in pilsner beers. J Inst Brew. 1985;91(1):37–40.
- Makkar HPS. Measurement of total phenolics and tannins using the Folin–Ciocalteu method. In: Quantification of Tannins in Tree and Shrub Foliage. Dordrecht: Springer; 2003. https://doi.org/10.1007/978-94-017-0273-7_3.
- Pant DR, Pant ND, Yadav UN, Khanal DP. Phytochemical screening and study of antioxidant, antimicrobial, antidiabetic, anti-inflammatory, and analgesic activities of extracts from the stem wood of Pterocarpus marsupium Roxburgh. J Intercult Ethnopharmacol. 2017;6(2):170.
- Ranjitha N, Krishnamurthy G, Manjunatha MN, Naik HB, Pari M, Vasantakumarnaik NK, et al. Electrochemical determination of glucose and H₂O₂ using Co(II), Ni(II), Cu(II) complexes of novel 2-(1,3-benzothiazol-2-ylamino)-N-(5-chloro-2-hydroxyphenyl) acetamide: synthesis, structural characterization, antimicrobial, anticancer activity, and docking studies. J Mol Struct. 2023;1274:134483.
- Chakraborty B, Raju SK, Abdulrahman IA, Karthikeyan P, Sreenivasa N, Kathirvel B. Streptomyces filamentous strain KS17 isolated from microbiologically unexplored marine ecosystems exhibited broad-spectrum antimicrobial activity against human pathogens. Process Biochem. 2022;117:42–52. https://doi.org/10.1016/j.procbio.2022.03.010.
- R C, Darshan, Kakkalameli SB. Phytochemical screening, proximate analysis and phytosynthesis of zinc oxide metallic nanoparticles from the leaf of Abutilon persicum (Burm. f.) Merr. and their biological applications. Asian J Appl Chem Res. 2025;16(2):173–200. https://doi.org/10.9734/ajacr/2025/v16i2337.
- Blois MS. Antioxidant determinations by the use of a stable free radical. Nature. 1958;181(4617):1199–200. https://doi.org/10.1038/1811199a0.
- Tolosa L, Donato MT, Gómez-Lechón MJ. General cytotoxicity assessment using the MTT assay. In: Vinken M, Rogiers V, editors. Protocols in In Vitro Hepatocyte Research. Vol 1250. New York: Humana Press; 2015. p. 333–48. https://doi.org/10.1007/978-1-4939-2074-7_26.
- Ismail M, Manickam E, Danial AM, Rahmat A, Yahaya A. Chemical composition and antioxidant activity of Strobilanthes crispus leaf extract. J Nutr Biochem. 2000;11(11–12):536–42.
- Tharmabalan RT. Nutritional profiles of four promising wild edible plants commonly consumed by the Semai in Malaysia. Curr Dev Nutr. 2023;7(4):100054.
- Singh D, Konsam SC, Singh K. Nutritive value of Strobilanthes auriculata Nees (Acanthaceae), a pliestial plant of Manipur, Northeast India.
- Tiong BYS, Yiong KH, Long W, Cheah AS, Abdul Sattar Y, Chang KA, et al. Strobilanthes crispus extract enhances attributes of yogurt: physicochemical properties, antioxidant activity, microbial viability, and consumer acceptability. J Culin Sci Technol. 2024;22(5):905–19.
- Essien KE, Udo ES, Okon OE, Owen AE. Evaluation of antinutritional, phytochemical, and mineral composition of Strobilanthes alternata leaves in Ikot Ekpene LGA of Akwa Ibom State, Nigeria. 2022.
- Fernandes MC, Krishnan S. Phytochemical analysis of Strobilanthes blume species from the Northern Western Ghats of India. 2016.
- Praveen T, Shreyas B, Prashanth K, Darshan RC, Siddappa BK. Phytochemical screening, GC–MS studies of Amorphophallus paeoniifolius (Dennst) Nicolson and its antimicrobial activity. Bull Environ Pharmacol Life Sci. 2025;14(2):15–23.
- KC CI, Indira G. Quantitative estimation of total phenolic, flavonoid, tannin, and chlorophyll content of leaves of Strobilanthes kunthiana (Neelakurinji). J Med Plants. 2016;4(4):282–6.
- Sundaram V, Sadhasivam S, Chandrasekaran S, Nanjian R, Pandian A. Strobilanthes heyneanus root extract as a potential source for antioxidant and antimicrobial activity. Future J Pharm Sci. 2021;7:1–12.
- Cheong BE, Zakaria NA, Cheng AYF, Teoh PL. GC–MS analysis of Strobilanthes crispus plants and callus. Trans Sci Technol. 2016;3(1–2):155–61.
- Aziz M, Ahmad S, Khurshid U, Pervaiz I, Lodhi AH, Jan N, et al. Comprehensive biological potential, phytochemical profiling using GC–MS and LC–ESI–MS, and in-silico assessment of Strobilanthes glutinosus Nees: an important medicinal plant. Molecules. 2022;27(20):6885.
- Suboh SF, Mahat AM, Yusof MH, Abdul Razak WRW. Antimicrobial activity of Strobilanthes crispus leaves aqueous extract and green biosynthesis of iron oxide nanoparticles against selected human pathogens. Asia Pac J Mol Biol Biotechnol. 2022;30(4):20–32.
- Nair VP, Parvathy AJ. FTIR spectroscopic studies on Strobilanthes ciliatus Nees (Bremek). Gyanshauryam Int Sci Refereed Res J. 2020;3:72–6.
- Balasubramaniam G, Sekar M, Badami S. In-vitro antioxidant and cytotoxic properties of Strobilanthes kunthianus. Res J Pharm Technol. 2021;14(5):2522–8.
- Ban WK, Fong IL, Khong HY, Phung JHY. Wound healing, antimicrobial, and antioxidant properties of Clinacanthus nutans (Burm. f.) Lindau and Strobilanthes crispus (L.) Blume extracts. Molecules. 2022;27(5):1722.
- Koh RY, Lim FP, Ling LSY, Ng CPL, Liew SF, Yew MY, et al. Anticancer mechanisms of Strobilanthes crispa Blume hexane extract on liver and breast cancer cell lines. Oncol Lett. 2017;14(4):4957–64.
- Gordani N, Cheong BE, Teoh PL. Antiproliferative effect of Strobilanthes crispus on MCF-7 cell line. Trans Sci Technol. 2017;4(3–3):414–9.
- Tan SA, Lim SY, Law CS, Yue CS, Poh TV, Saad WZ, et al. Antioxidative and photocytotoxic effects of standardised Clinacanthus nutans and Strobilanthes crispus extracts toward HepG2 liver cells. Pharmacogn Mag. 2019;15(65).
- Praveen T, Kakkalameli SB. Studies on phytochemical, GC–MS analysis, in vitro cytotoxic assay, and biological activities of Cynarospermum asperrimum (Nees) Vollesen (Acanthaceae). 2025.